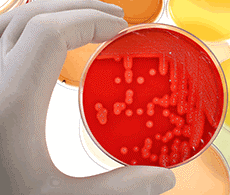

28.03.2016
Gibco (Thermo) - это среды, сыворотки и воспомогательные реагенты для работы с культурами клеток млекопитающих и насекомых, для культивирования
стволовых клеток, для получения и ращения первичных культур из различных типов клеток.
Gibco (Thermo) предлагает продукцию не только для исследовательских, но и для практических целей, например, для клеточной терапии.
Gibco (Thermo) предоставляет услуги по разработке и оптимизации биотехнологических производств, связанных с клеточными культурами, по разработке
ростовых сред, оптимизированных под конкретную задачу, библиотеку протоколов для работы с клеточными культурами или онлайн-конфигуратор
культуральной среды.
|

|
1. Среды для эукариотических клеток
- Классические среды
- Модифицированные среды
- Специальные среды для разных типов клеток
2. Компоненты сред
- Сыворотки
- Питательные добавки
- Антибиотики, антимикотики
- Ростовые факторы, компоненты внеклеточного матрикса и др.
3. Реагенты для работы с клеточными культурами
- Реагенты для клеточной диссоциации
- Реагенты для замораживания клеток
- Реагенты для трансфекции
- Реагенты для цитогенетических исследований
4. Среды и реагенты для работы с бактериями и дрожжами
5. Первичные культуры клеток млекопитающих и реагенты для работы с ними
6. Реактивы, среды и воспомогательные материалы для цитогенетических исследований
1. Среды для эукариотических клеток

|
Классические среды
- DMEM, МЕМ, 199, RPMI, применяемые для выращивания широкого спектра клеточных культур; как в готовом виде, так и в виде порошков или концентратов, в различных фасовках, с индикатором кислотности и без.
|
Модифицированные среды
- Серия GlutaMAX – среды с аналогом глютамина (необходимого компонента культуральной среды), обладающим высокой стабильностью и дающий возможность более длительного инкубирования культуры без замены среды. В модификации GlutaMAX выпускаются все классические среды.
- Серия Advanced – среды, обогащенные компонентами сыворотки и поэтому требующие добавления фетальной сыворотки только до 2%.
- Среда FluoroBrite DMEM для флюоресцентной микроскопии живых клеток.
- DMEM/F12 - улучшенный вариант DMEM, содержащий питательную смесь F12.

|
Специальные среды для разных типов клеток и различных задач
- Среды для культуры клеток яичников китайского хомячка (CHO): Ham’s F10 и Ham's F12, оптимизированные для выращивания клеток CHO.
- Среды для работы со стволовыми клетками дают возможность сохранять недифференцированность стволовых клеток в течение многих пассажей. Essential 8 для плюрипотентных стволовых клеток, среды В-27 и Neurobasal для стволовых клеток нервной системы, серия StemPro – для мезенхимальных стволовых клеток.
- Среды для работы с клетками насекомых: Грейса (Grace's Insect Media), серия Sf-900 - специальные улучшенные среды для экспрессии белков в клетках насекомых.
- Специализированные среды для работы с первичными культурами клеток человека и животных.
- среды для экспрессии белков в клетках млекопитающих – FreeStyle 293 Expression, FreeStyle CHO Expression, Expi293 Expression. Эти среды являются частью наборов для трансфекции и анализа экспрессии FreeStyle MAX System и Expi293 Expression System Kit
- Среда для трансфекции с помощью катионных липосом Opti-MEM - модификация среды Игла, содержащую буферный раствор, гипоксантин, тимидин, пируват и ряд ростовых факторов и микроэлементов.
|
2. Компоненты сред
- Эмбриональная телячья сыворотка (ЭТС, FBS) серии Standard и Performance отличаются степенью чистоты и содержанием эндотоксинов.
- Сбалансированные солевые растворы нужны для обеспечения правильной структуры и физиологической целостности клеток.
- Добавки для выращивания клеток: меркаптоэтанол (в качестве антиоксиданта), смесь аминокислот, инсулин, глюкоза и др. питательные вещества, антибиотики и антимикотики (для защиты клеток или в качестве факторов селекции). Надо также отметить устройства Lab Armor Beads, представляющие собой аналоги водяной бани, не требующие воды или льда (для предотвращения контаминации).
- Ростовые факторы, цитокины и хемокины для различных типов клеток из различных организмов. С целью обеспечения чистоты препарата и его качества Gibco (Thermo) предлагает только рекомбинантные ростовые факторы, цитокины и хемокины. Можно сформировать набор ростовых факторов в зависимости от источника культивируемых клеток (человек, мышь, крыса и т.д.), типа клеток (стволовые клетки, опухолевые клетки, клетки иммунной системы, нервные клетки) или цели исследования (получение культуры клеток, исследование сигнальных межклеточных путей, клинические исследования).
3. Реагенты для работы с клеточными культурами
Эти реагенты напрямую не связаны с культивированием клеток, но необходимы для работы с клеточными культурами.

|

|
- Реагенты для диссоциации клеток – трипсин и трипсин-содержащие растворы, коллагеназа, диспаза, реагенты серии TrypLy.
- Буферные растворы PBS в различных вариантах.
- Реагенты для трансфекции. Одним из наиболее широко применяемых реагентов для трансфекции является катионный липид Lipofectamine в различных модификациях, предназначенных для трансфекции плазмидной ДНК или микроРНК в различные типы клеток. Также Gibco (Thermo) предлагает реагент Invivofectamine для трансфекции in vivo.
|
4. Среды и реагенты для работы с бактериями и дрожжами

|

|
- Cреды и компоненты сред для выращивания бактерий: жидкая среда и агар LB, минимальная среда М9, специализированная среда MagicMedia для работы с Т7-регулируемыми штаммами; индукторы (IPTG) и антибиотики.
- Cреды и компоненты сред для выращивания дрожжей: универсальная среда YPD, среда CSM для S. cerevisiae, среда PichiaPink для P. pastoris; наборы для трансформации дрожжей.
- Среды для выращивания одноклеточных водорослей и цианобактерий: среда TAP Growth, оптимизированная для Chlamydomonas, и среда BG-11, оптимизированная для Сyanobacteria.
|
5. Первичные культуры клеток млекопитающих и реагенты для работы с ними
Все первичные культуры
Gibco (Thermo) охарактеризованы.
- Первичные культуры различных типов клеток: эпителий роговицы, фибробласты, гепатоциты, кератиноциты, меланоциты, эпителий молочных желез, эндотелиоциты различных типов, нервные клетки, мышечные клетки – человеческие, мышиные, крысиные.
- Культуры стволовых клеток: плюрипотентные, нервные, мезенхимальные, клетки кроветворения. Одна из задач при культивировании стволовых клеток – поддерживание их в недифференцированном состоянии. Поэтому Gibco (Thermo) разработал заменитель сыворотки Knockout SR, не содержащий факторов дифференцировки, а также полная среда для эмбриональных клеток Knockout ESC/iPSC. Также имеется среда Essential 8 Medium, позволяющая эмбриональным клеткам сохранять свою плюрипотентность в ходе культивирования.
- Среды и другие реагенты (криоконсерванты, факторы роста и дифференцировки, биомаркеры), а также флаконы и подложки для работы с первичными культурами.

|
Системы для экспрессии рекомбинантных белков
Клеточные линии для экспрессии в клетках насекомых: Drosofila S2 для экспрессии гетерогенных белков в системе экспрессии DES (drosophila expression system) и High Five, оптимизированную под бакуловирусную систему экспрессии.
|
6. Реактивы, среды и воспомогательные материалы для цитогенетических исследований

|
- Серия AminoMAX для работы с культурой клеток из амниотической жидкости или ворсинок хориона.
- Серия MarrowMAX для одной из самых трудных для выращивания клеточных культур – клеток костного мозга.
- Серия PB-MAX и KaryoMAX для культивирования лимфоцитов периферической кровеносной системы с целью кариотипирования; содержат синтетический аналог колхицина, останавливающий процесс митоза на стадии метафазы, что помогает визуализировать хромосомы.
|
7.
Среды, реагенты и технические решения для клеточной терапии
Продукты серии CTS (Cell Therapy System) для внедрения в клиническую практику результатов экспериментов в области клеточной терапии. В данную серию входят среды, реактивы, ростовые факторы, ферменты и др., предназначенные для выращивания в терапевтических целях плюрипотентных стволовых клеток, клеток иммунной системы для иммунотерапии, мезенхимальных стволовых клеток для восстановления тканей и т.д. Особенностью данной серии является то, что все продукты валидированы и сертифицированы для клинического применения.